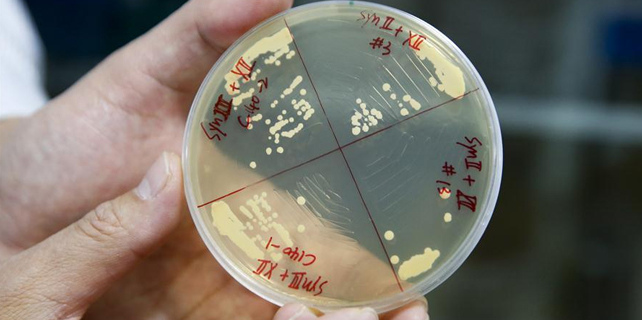

Wrap-up: Ministers address journalists
2017-03-12 14:38
Forum Trends: Should bride prices be abolished?
2017-03-12 09:34
Syria bomb attacks claim 40 Iraqi lives
2017-03-12 07:31
China to launch all 15 big science projects this year
2017-03-11 15:45
Sowing seeds for a greener China
2017-03-12 06:48
'Seagull mother' feeds thousands of birds at own expense
2017-03-11 08:56
Grassroots NPC deputy proposes cashless cities
2017-03-10 15:23
Chinese scientists create 4 synthetic yeast chromosomes
2017-03-11 16:44
Super cute: When animals meet the beauty filter app
2017-03-10 14:51
Overview: Draft general provisions of civil law
2017-03-10 09:28
Chinese Super League week one: Five things we learned
2017-03-10 11:23Review of China key 2016 economic figures
2017-03-10 06:35
Ten photos from across China: March 3-9
2017-03-10 06:30
Baobao adapts to new environment, food in Sichuan
2017-03-10 07:56